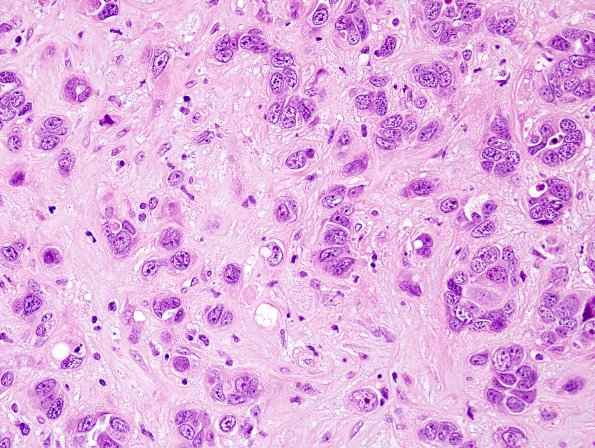
83A4 Metastases, breast (Case 83) H&E 6.jpg

Table of Contents
Washington University Experience | NEOPLASMS (METASTASES) | Microscopic | 83A4 Metastases, breast (Case 83) H&E 6.jpg
Case 83 History ---- The patient is a 51 year old woman with a history of breast carcinoma, now presenting with an enhancing dural based mass in the left frontal lobe. Operative procedure: Left frontal craniotomy for tumor resection. ---- 83A1-4 Sections of the left frontal mass show nests of neoplastic cells also forming ductular structures. The neoplastic cells have a high nuclear to cytoplasmic ratio, with round monotonous hyperchromatic nuclei. Numerous mitoses are seen.